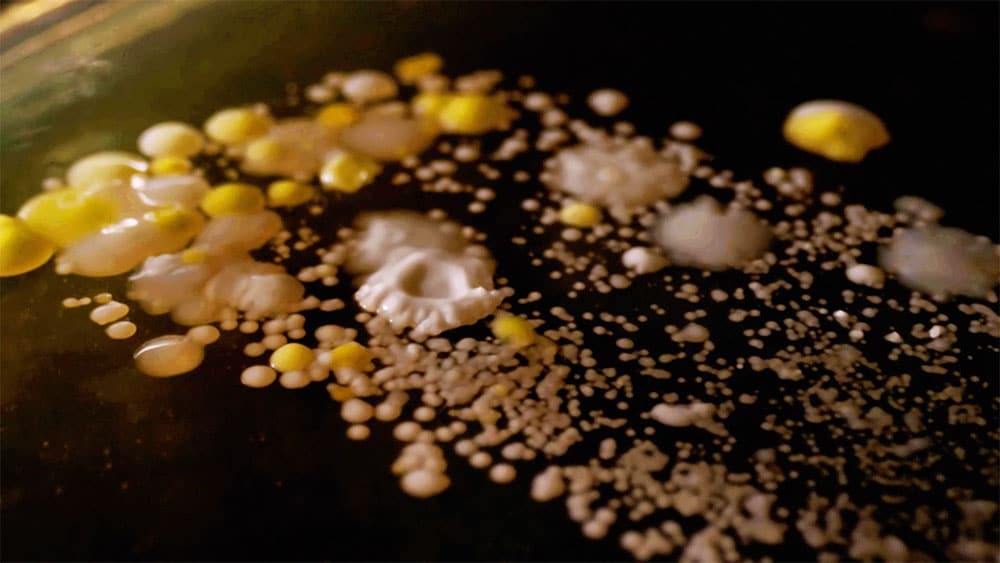
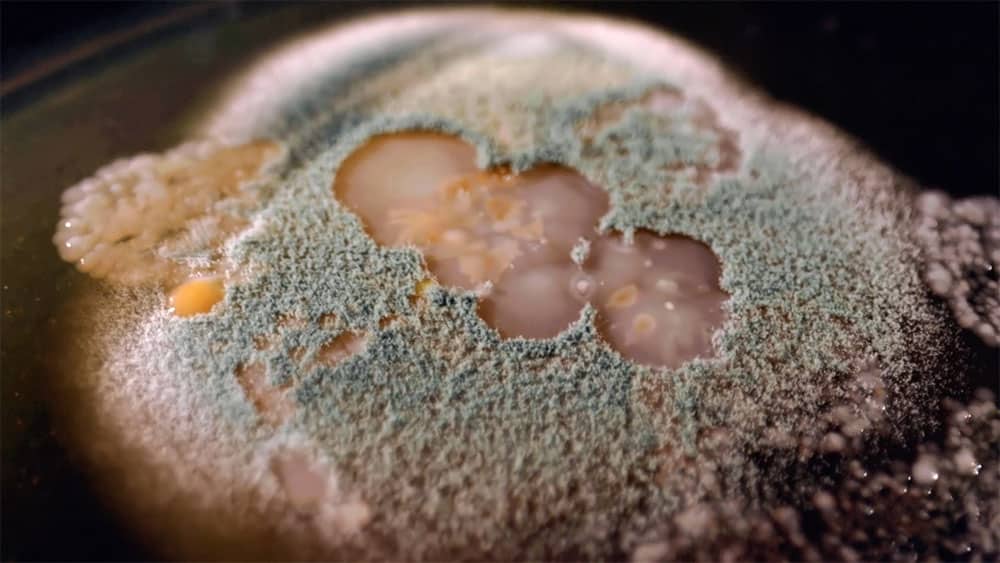
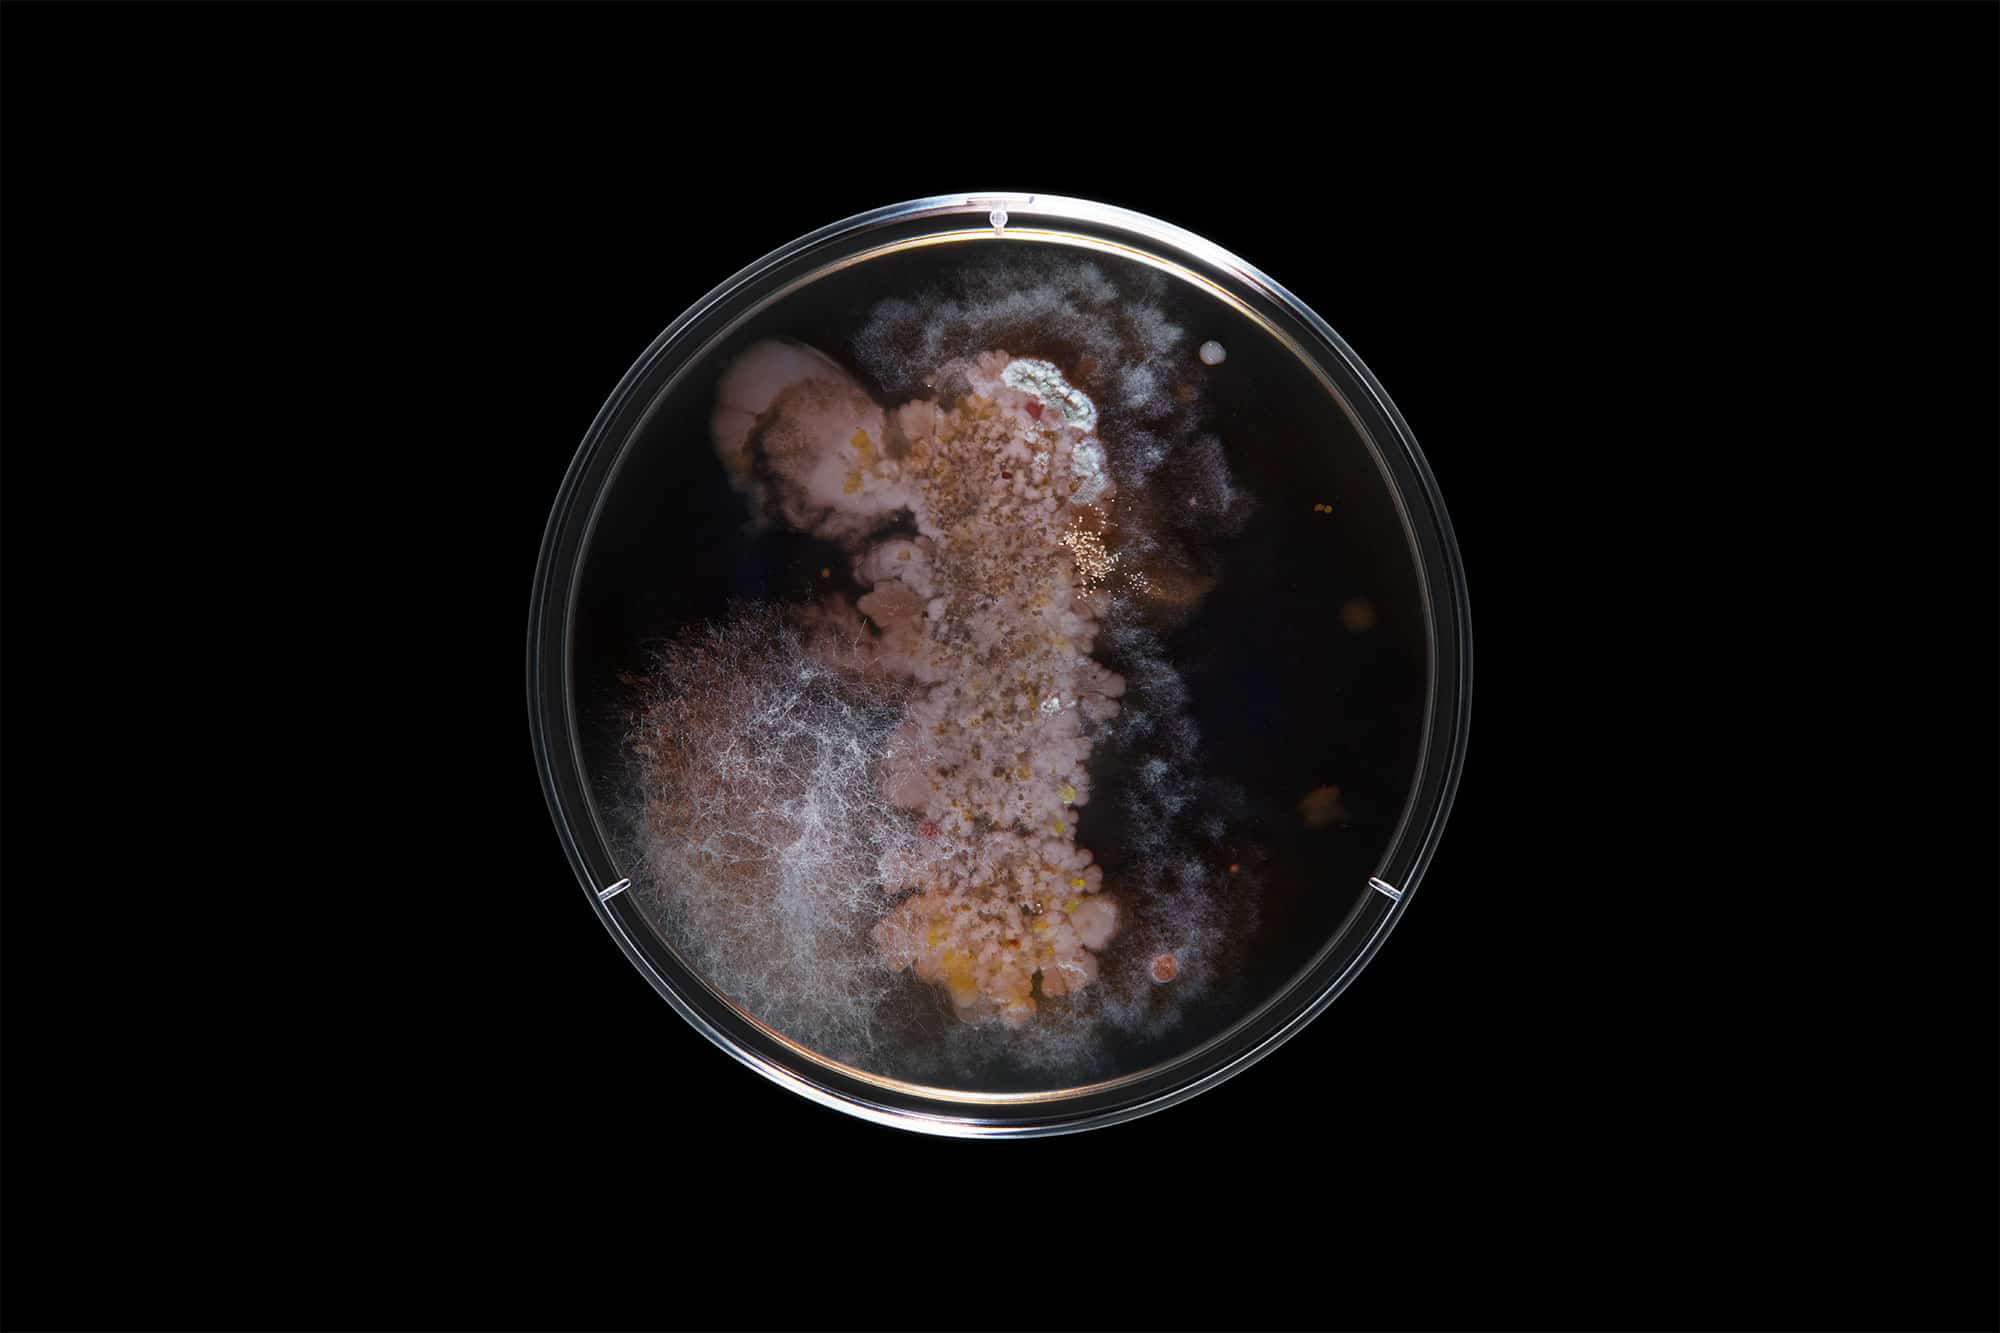
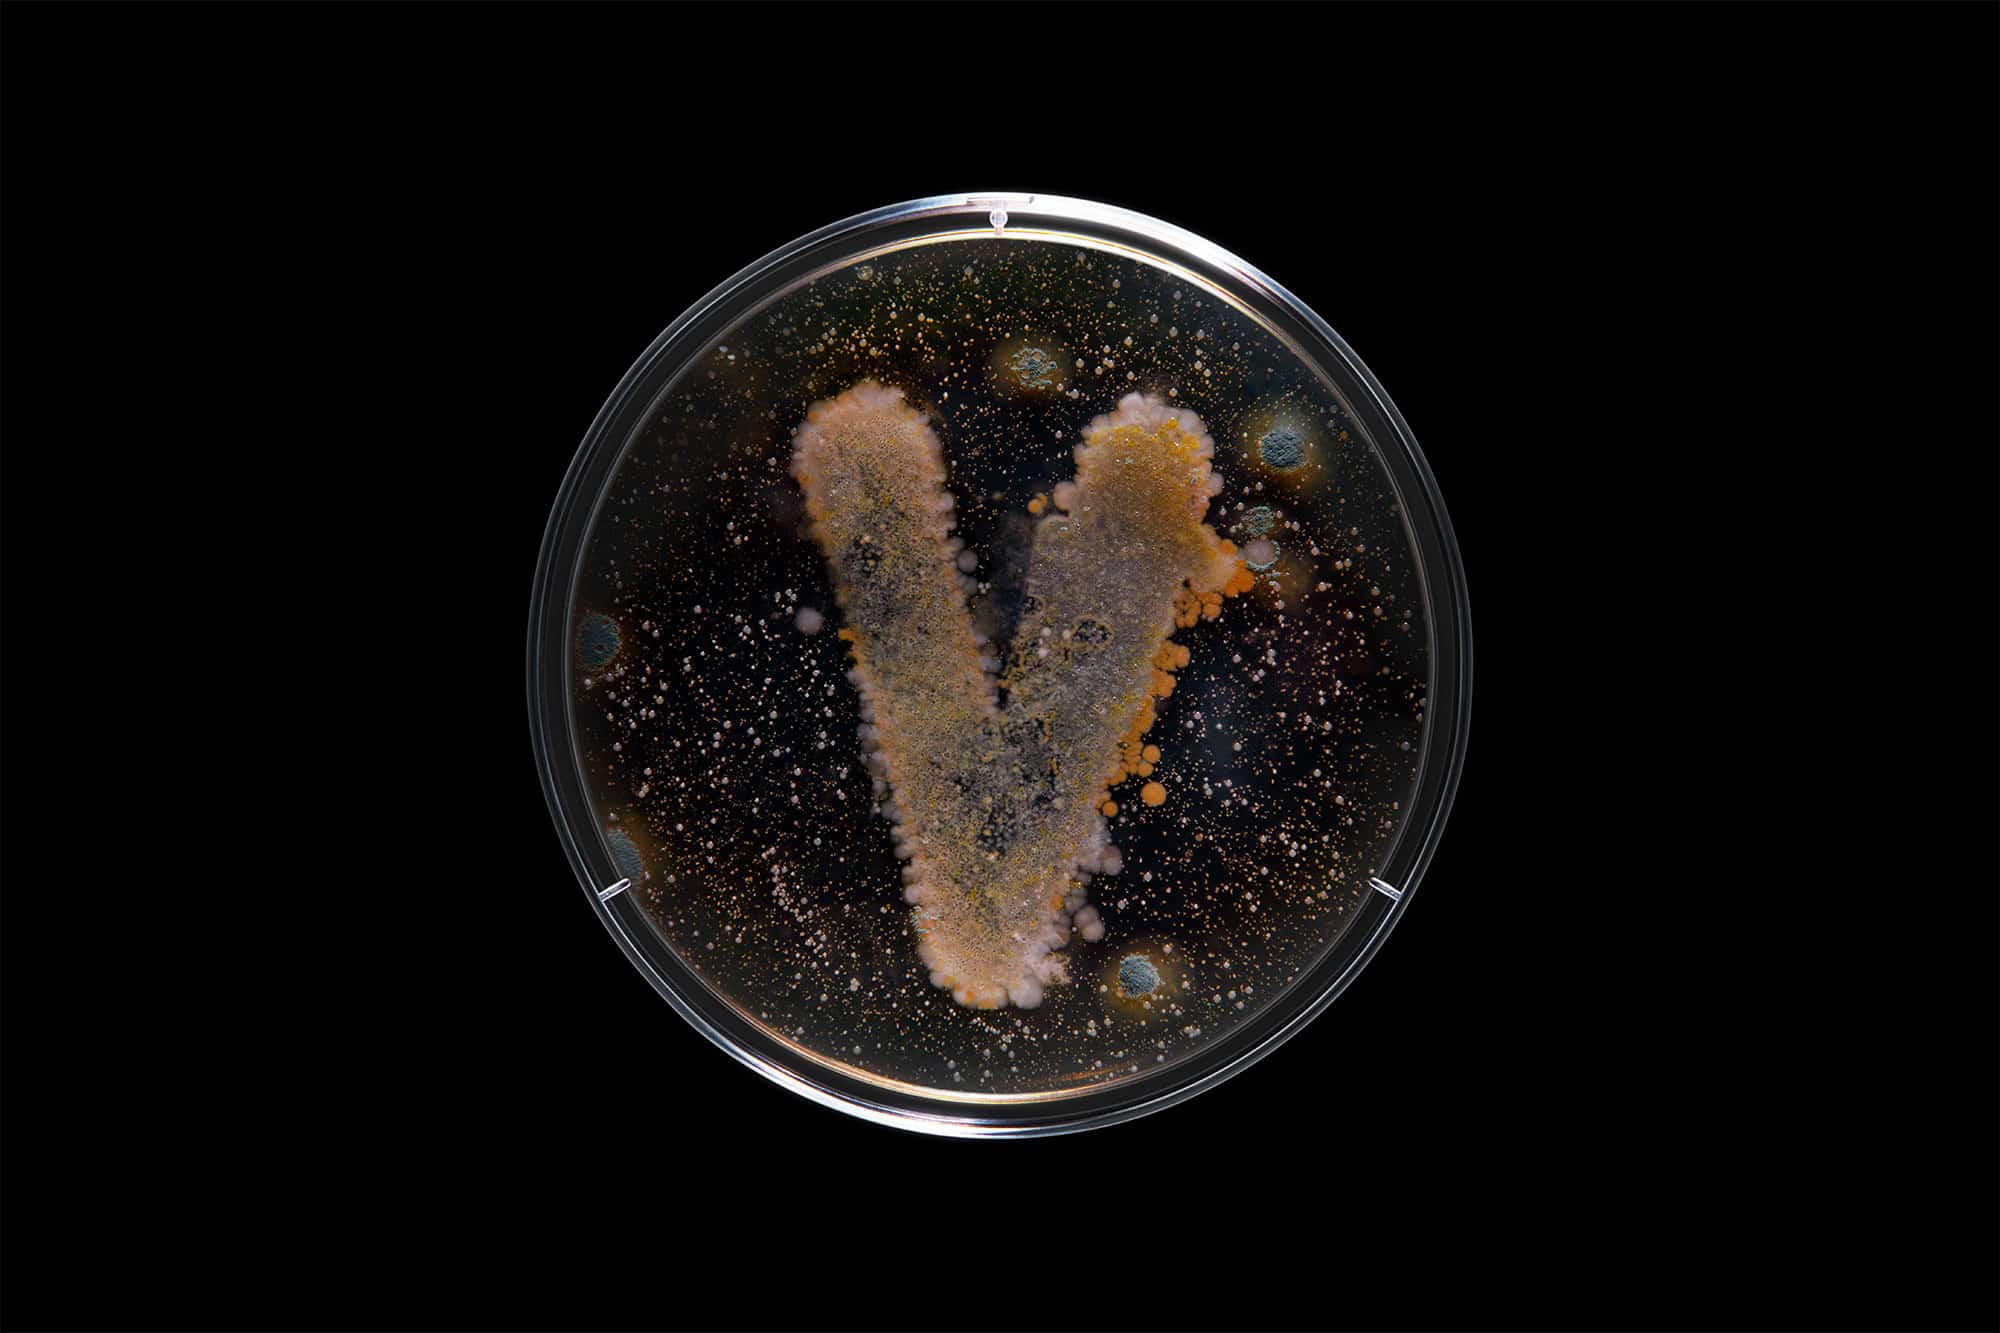
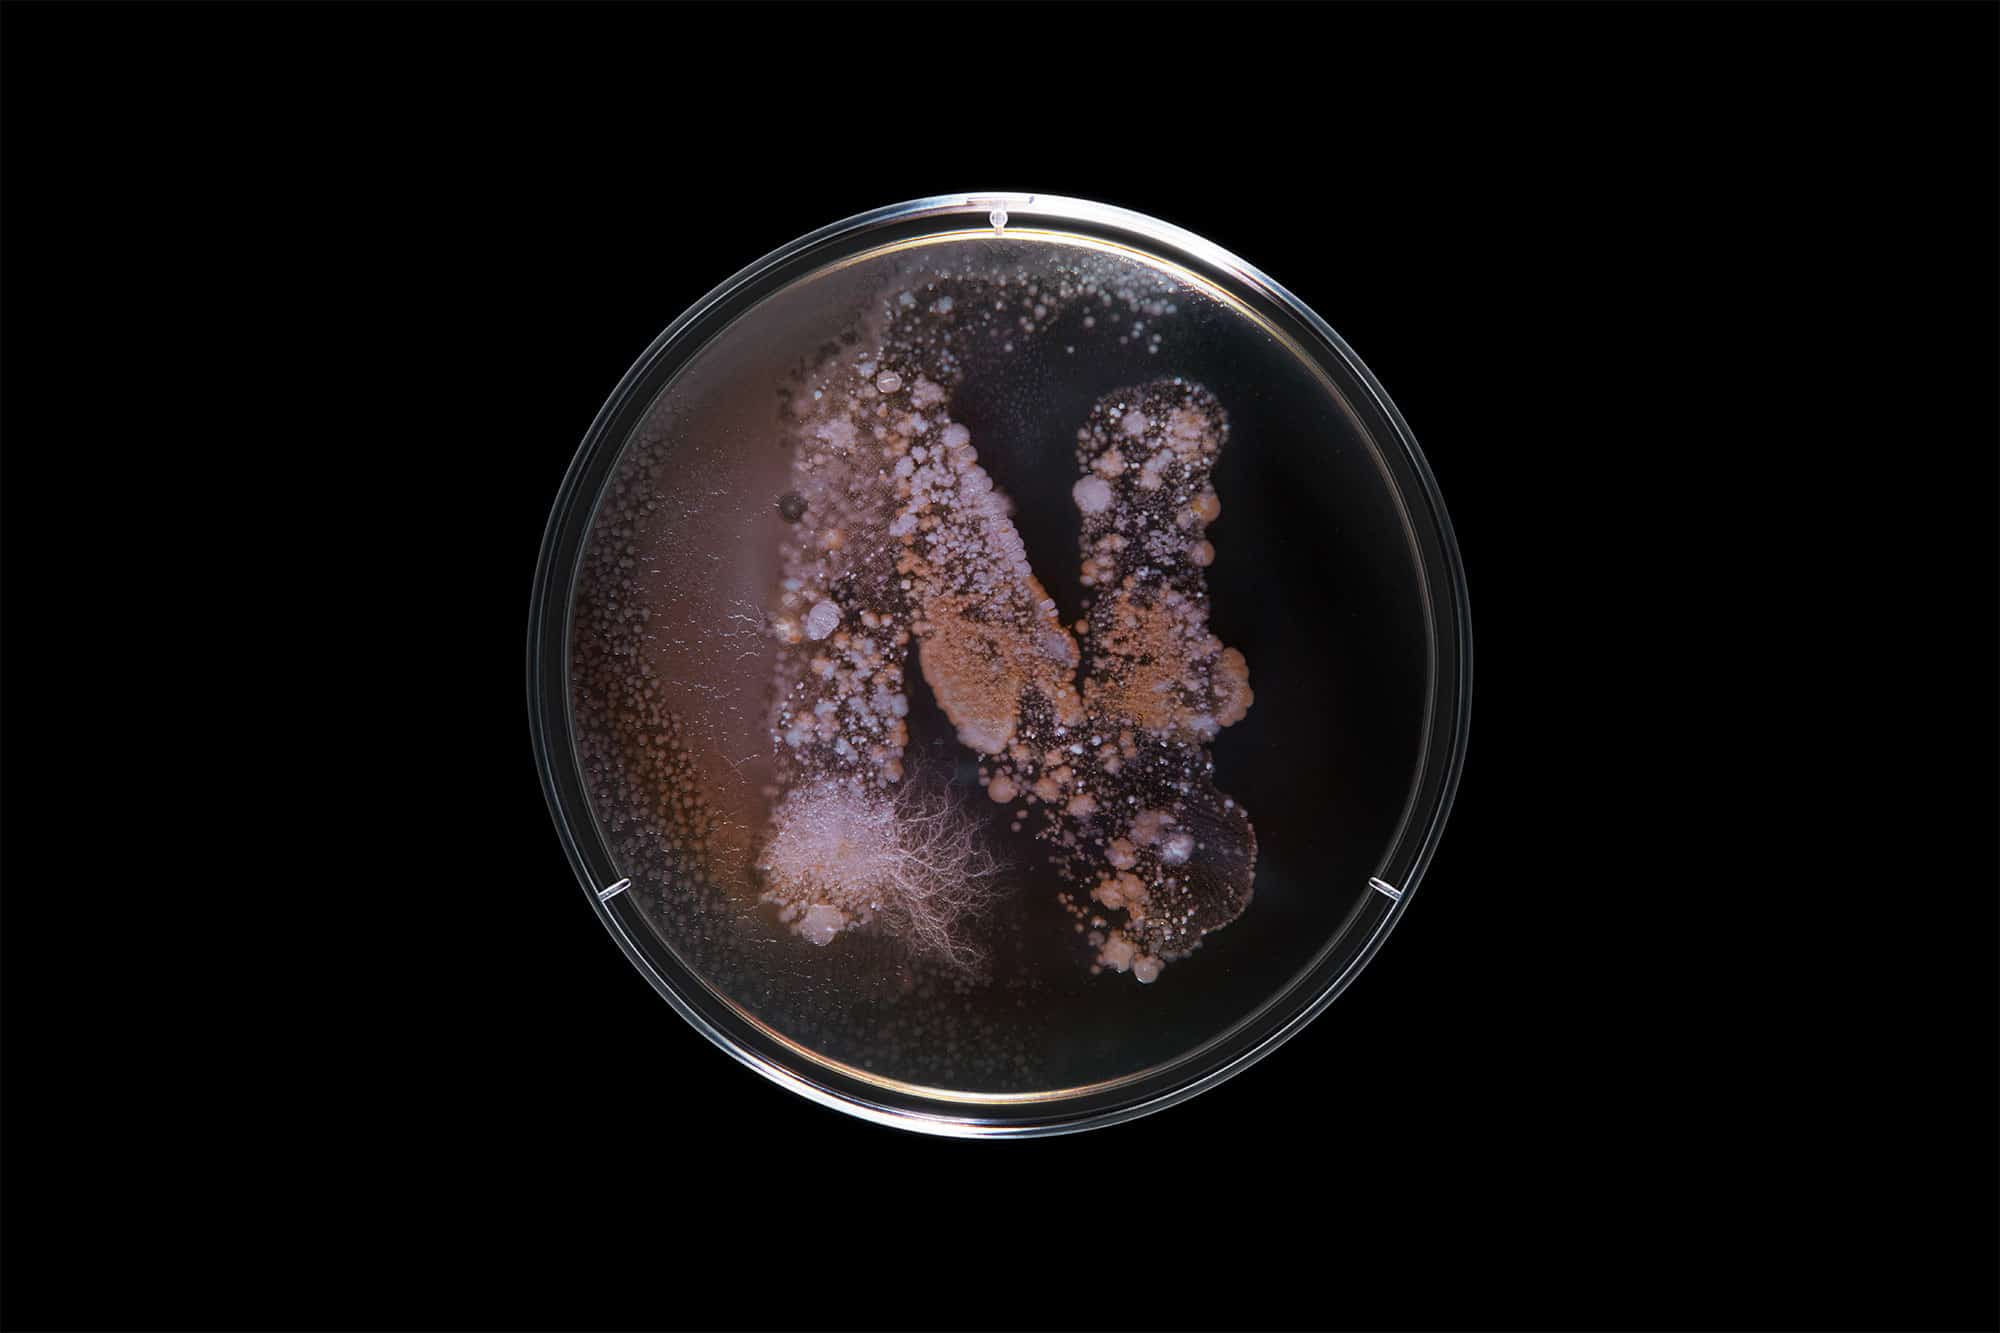
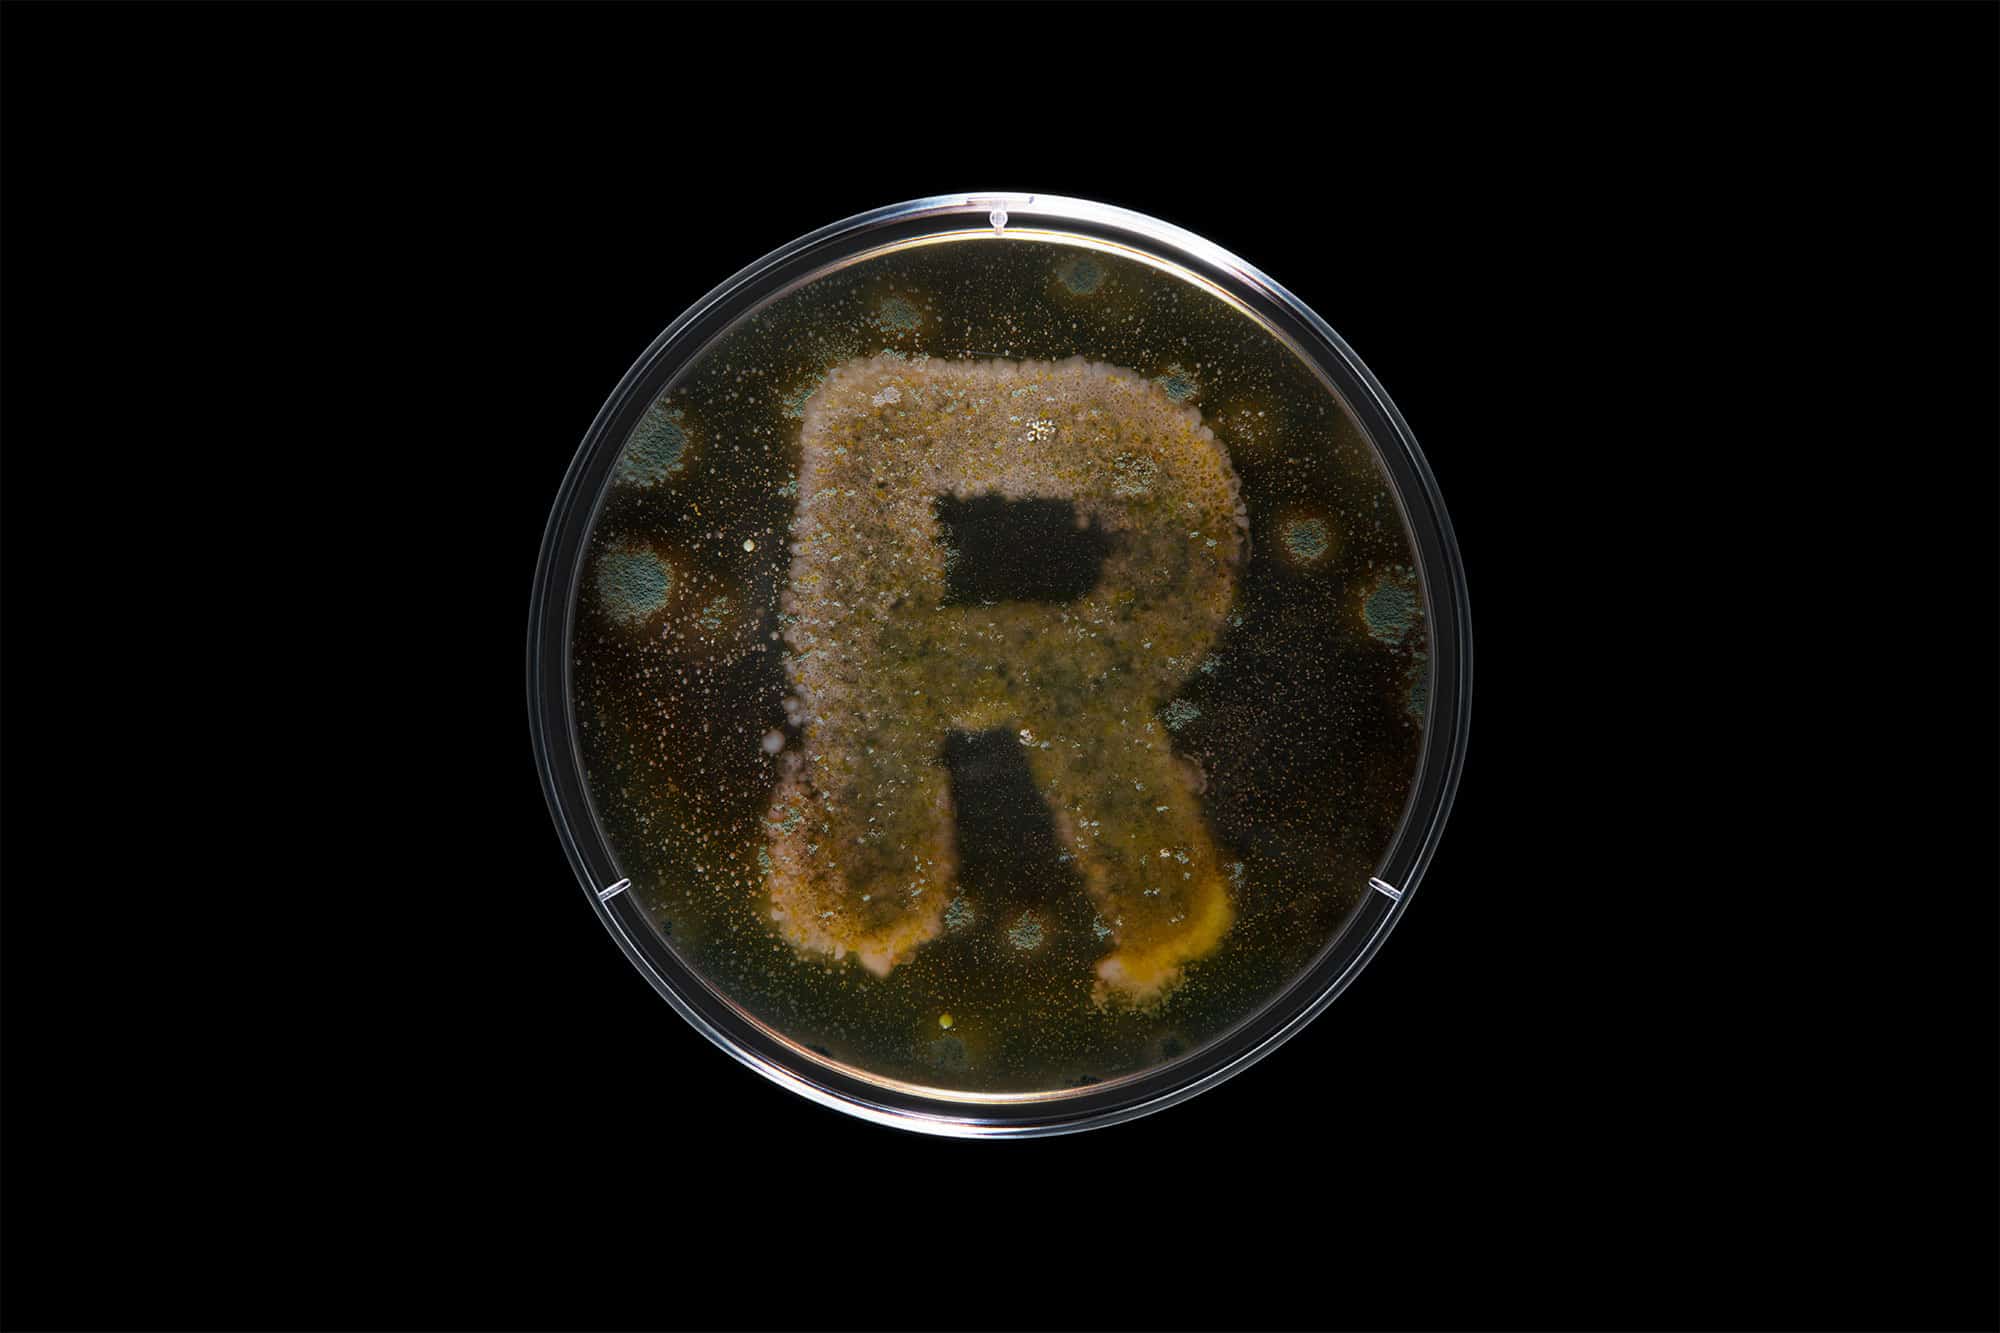

A living, breathing alphabet created through microscopic growth and digital innovation.
Partnering with Rapp and Kyowa Kirin, we were tasked with wrangling live bacteria cultures to form a complete typeface for a hero film and stills. We balanced real-world biological growth with digital control, acting as both biochemists and motion designers to capture the authentic movement and organic textures of these microscopic environments.
Merging practical bio-cultures with sophisticated digital enhancements. Our concept centered on the idea ‘From Our Culture To Yours,’ blending macro cinematography with subtle VFX to bring the living alphabet to life. This project highlights our passion for experimental craftsmanship, pushing the boundaries of traditional motion design to deliver a visceral and impactful campaign for the pharmaceutical sector.